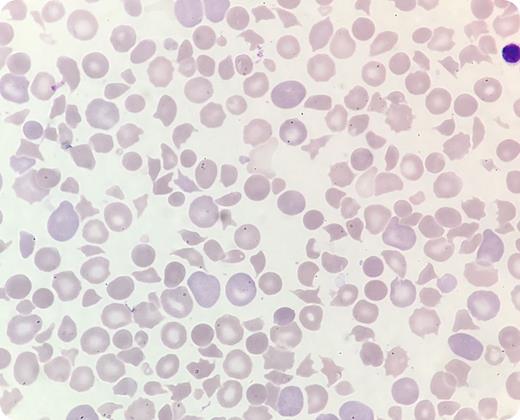
A presumably healthy full-term boy developed icterus shortly after birth. He was irritable and had ecchymoses on his heels and low oxygen saturation (85%). Venous blood gas analysis showed acidosis (pH 7.16) and elevated lactate (5.1 mmol/L). Sepsis or congenital heart failure was suspected. Echocardiography was normal. Blood tests taken 28 hours after birth showed hemoglobin 135 g/L, white cell count 30 × 109/L, platelet count 6 × 109/L, and negative direct antiglobulin test. A peripheral blood smear revealed pronounced anisopoikilocytosis with 28% schistocytes and confirmed thrombocytopenia (May-Grünwald Giemsa stain; original magnification ×100). This was reported to the pediatrician, who immediately prescribed red blood cells and platelets. However, the patient’s condition deteriorated. Bilirubin was highly elevated (32.8 mg/dL). Treatment with immunoglobulins and phototherapy was initiated, but he died 34 hours after birth. Autopsy was inconclusive. / Postmortem, on the basis of laboratory findings and blood smear examination, the clinical pathologist suggested the possibility of hereditary thrombotic thrombocytopenic purpura (TTP). Genetic tests confirmed biallelic ADAMTS13 gene mutations. Hereditary TTP caused by ADAMTS13 mutations is a rare but serious condition, often presenting during the newborn period with thrombocytopenia and microangiopathic hemolytic anemia. It is vital that health professionals recognize TTP in newborns to avoid fatal outcomes as in this case.

A presumably healthy full-term boy developed icterus shortly after birth. He was irritable and had ecchymoses on his heels and low oxygen saturation (85%). Venous blood gas analysis showed acidosis (pH 7.16) and elevated lactate (5.1 mmol/L). Sepsis or congenital heart failure was suspected. Echocardiography was normal. Blood tests taken 28 hours after birth showed hemoglobin 135 g/L, white cell count 30 × 109/L, platelet count 6 × 109/L, and negative direct antiglobulin test. A peripheral blood smear revealed pronounced anisopoikilocytosis with 28% schistocytes and confirmed thrombocytopenia (May-Grünwald Giemsa stain; original magnification ×100). This was reported to the pediatrician, who immediately prescribed red blood cells and platelets. However, the patient’s condition deteriorated. Bilirubin was highly elevated (32.8 mg/dL). Treatment with immunoglobulins and phototherapy was initiated, but he died 34 hours after birth. Autopsy was inconclusive.
Postmortem, on the basis of laboratory findings and blood smear examination, the clinical pathologist suggested the possibility of hereditary thrombotic thrombocytopenic purpura (TTP). Genetic tests confirmed biallelic ADAMTS13 gene mutations. Hereditary TTP caused by ADAMTS13 mutations is a rare but serious condition, often presenting during the newborn period with thrombocytopenia and microangiopathic hemolytic anemia. It is vital that health professionals recognize TTP in newborns to avoid fatal outcomes as in this case.
A presumably healthy full-term boy developed icterus shortly after birth. He was irritable and had ecchymoses on his heels and low oxygen saturation (85%). Venous blood gas analysis showed acidosis (pH 7.16) and elevated lactate (5.1 mmol/L). Sepsis or congenital heart failure was suspected. Echocardiography was normal. Blood tests taken 28 hours after birth showed hemoglobin 135 g/L, white cell count 30 × 109/L, platelet count 6 × 109/L, and negative direct antiglobulin test. A peripheral blood smear revealed pronounced anisopoikilocytosis with 28% schistocytes and confirmed thrombocytopenia (May-Grünwald Giemsa stain; original magnification ×100). This was reported to the pediatrician, who immediately prescribed red blood cells and platelets. However, the patient’s condition deteriorated. Bilirubin was highly elevated (32.8 mg/dL). Treatment with immunoglobulins and phototherapy was initiated, but he died 34 hours after birth. Autopsy was inconclusive.
Postmortem, on the basis of laboratory findings and blood smear examination, the clinical pathologist suggested the possibility of hereditary thrombotic thrombocytopenic purpura (TTP). Genetic tests confirmed biallelic ADAMTS13 gene mutations. Hereditary TTP caused by ADAMTS13 mutations is a rare but serious condition, often presenting during the newborn period with thrombocytopenia and microangiopathic hemolytic anemia. It is vital that health professionals recognize TTP in newborns to avoid fatal outcomes as in this case.
For additional images, visit the ASH Image Bank, a reference and teaching tool that is continually updated with new atlas and case study images. For more information, visit http://imagebank.hematology.org.